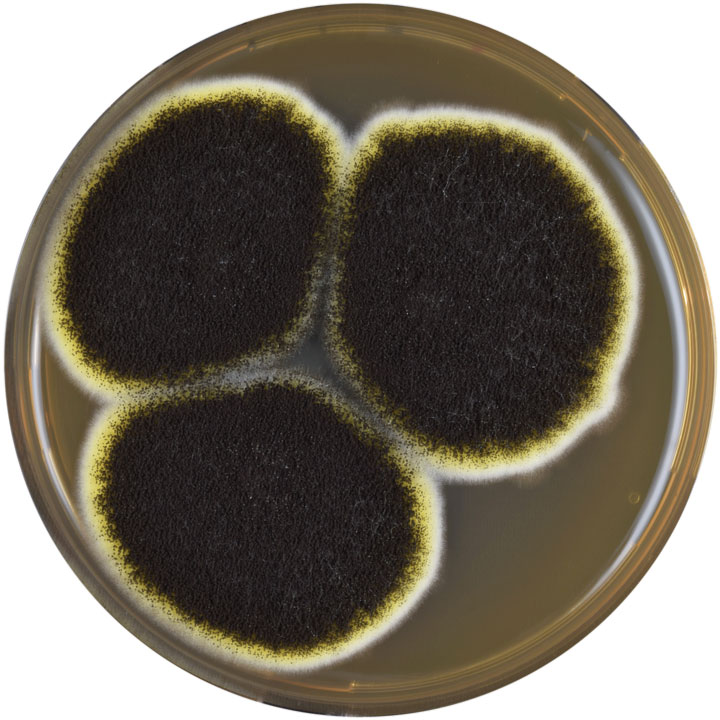

Brewing Up a Storm: The Origins of Biotechnology Part 1
In this contribution to his series about chemical engineering history, Martin Pitt turns his focus onto the interesting developments in biotechnology
BIOTECHNOLOGY is as much an exciting part of chemical engineering today as it is promising for its future. In this two-part article I will look at its long use, and how it suddenly changed the world. Here are some of the microbes and how they have helped us for many years.
The useful yeast
As a child in Burton-on-Trent, my abiding memory is the smell of Marmite as I looked across the river from my school to the big “Bass” sign on the brewery. The dark spread that people either love or hate is an extract of brewer’s yeast, a by-product of beer production. This is where the industrial process began in 1902, scaled up from a method developed by the famous German chemist and pioneer of nutritional science, Justus von Liebig (1803–1873).
Brewing is the archetypal biological synthesis of a mass product – an impure solution of ethanol in water which has found extensive use in human society. Ethanol is a toxic product excreted by yeast during its growth under low-oxygen conditions. If it’s not removed, it inhibits the yeast, which limits the concentration which can be produced without further processes, notably distillation. To make Marmite and similar products, the yeast is separated, some is saved for further brewing or other uses, then the rest is treated with salt and heat to break down the cells and screened to remove husks. Additional vitamins and flavours may be added.

Brewing and winemaking have been done for 7,000 years, and for nearly all of these they were considered women’s work, along with making risen bread, which also uses yeast. A 4,000-year-old hymn to the goddess of beer, Ninkasi, includes a recipe for making beer from bread. In the 21st century, there were excited newspaper articles about new beers made from waste bread from supermarkets and sandwich makers.
Yeast for beer or wine is a sort of fungus, like mushrooms and mould, so are the organisms which nowadays make penicillin, other antibiotics, and citric acid. Acetone, butanol, and glutamic acid are produced by bacteria. All of these are fermentation, a process first understood by Louis Pasteur (1822–1895) in 1857, which he described as “a form of life without air” which led to the word anaerobic. His research for wine and beer industries were crucial in understanding the processes of microorganisms, making him the “father of microbiology”. His realisation that living organisms were involved led to pasteurisation (heating to kill them) to prevent spoiling of wine and milk, and to the germ theory of disease and its prevention.
Saccharomyces cerevisiae is brewer’s or baker’s yeast and is also the one most commonly used to produce wine, where the vintner does not rely solely on environmental yeasts. It’s a top-fermenting yeast because the production of carbon dioxide causes flocs of living and dead yeast to rise to the surface in a natural version of froth flotation. This foamy mess is called barm and is skimmed off to be used by bakers. Someone who is “barmy” is someone with froth in their head.

The material which settles in the bottom of wine is called lees, and contains the acid salt potassium bitartrate discovered by chemist Carl Wilhelm Scheele (1742–1786) in 1769. It reacts to form CO2 with sodium bicarbonate causing baked goods to rise quicker and without yeast. Combining the two in baking powder revolutionised commercial baking in the late-19th century.

(Pasteur’s) realisation that living organisms were involved led to pasteurisation (heating to kill them) to prevent spoiling of wine and milk, and to the germ theory of disease and its prevention

Yeast was specially grown from potatoes for bakers in vats in the UK from 1879. Filter presses and later centrifuges allowed the production of solid cakes for this purpose. This is now the usual source for baking, and a slightly different strain from that used by brewers. Hence the spare yeast at Bass and the new profit from Marmite.
Ale is brewed at 16–24°C and is more fruity than lager, (brewed at 6–12°C with Saccharomyces pastorianus, a yeast named after Pasteur). In the wild state, ale or wine yeasts give off odours to attract fruit flies, which then carry spores elsewhere. The slower rate of fermentation in lager brewing means that yeast is not carried to the surface, so it’s called bottom-fermenting. However in both cases it’s yeast that is dispersed which is the major fermenter.
Lager yeasts were produced by natural selection for cold tolerance by Bavarian brewers storing barrels in mountain caves or in cold cellars (“to store” is “lagern” in German). Mass production depended on industrial refrigeration from the late-19th century.
Beer-making is a complex process but reasons were not understood until after Pasteur. Eduard Buchner (1860–1917) got the Nobel Prize in 1907 “for the discovery of cell-free fermentation”, i.e. the enzyme zymase extracted from yeast, which converts sugar into ethanol and CO2. It’s not only the enzymes from yeast which are involved, but in an earlier stage known as malting, wet grain is allowed to partially germinate, then milled and mashed, i.e. mixed with warm water. The plant enzymes break down starch into simpler sugars and produce other compounds for cell construction, all intended to grow corn. Instead, the sweet liquor called wort is separated and boiled to sterilise it before adding the yeast which feeds off this ideal liquid. Hops or other flavouring agents are usually added during wort boiling, and further separation takes place before the yeast is added.
In the 19th century, chemical engineering methods displaced some of the traditional ones, with better process control, particularly of temperature, as well as less manual handling.
A major triumph of chemical engineering was converting distillation and some chemical reactions from batch processes to continuous ones, giving greater efficiency. This has been more of a challenge for bioreactors. Brewing is especially difficult because it’s not merely the production of a chemical, but a whole complex of flavours. In the fermentation process especially (but also in the germination and mashing), there is a sequence of enzymatic reactions, and so a sequential tank system was introduced in New Zealand in 1957 and is still used commercially. A tower system came into production in the UK in 1970 – a continuous flow reactor acting like a sequence of batch ones.
A brewing research scientist told me: “We spent ten years trying to get the continuous product to match the batch one, and failed. Then they realised it was better to spend money on marketing than on science. Let the taste come out as it did, then tell the target audience how much they liked it, and how it was drunk by handsome, sexually-successful men. The youngsters soon learned.”

A major triumph of chemical engineering was converting distillation and some chemical reactions from batch processes to continuous ones...This has been more of a challenge for bioreactors
The butanol bacillus
Having understood ethanol, Pasteur thought biosynthesis of butanol might be possible, and demonstrated it with bacteria in 1861. In the early 1900s, the British company Strange and Graham funded research with both Auguste Fernbach (1860–1939), at the Institut Pasteur, and Chaim Weizmann (1874–1952), at the University of Manchester, to find microorganisms and methods for butanol in order to make synthetic rubber. Fernbach found one which produced acetone and butanol, which the company patented and started production in 1912, the first modern biotech plant.
However, it was a better bacterium, Clostridium acetobutylicum, isolated by Weizmann, which went into production in 1915 during the British war effort in WW1. This was known as the ABE process because it gave acetone, butanol and ethanol in the ratio 3:6:1. Acetone was needed for the manufacture of cordite. Larger production began in Canada in 1916 by British Acetone and the USA in 1917 by The Commercial Solvents Corporation.

After the War, Henry Ford (1863–1947) needed a quick-drying lacquer for his automobiles, and butanol turned out to be ideal, causing many plants to be set up as the motor industry expanded. Acetone was again wanted in WW2 and butanol had many uses, including as a replacement for, or mixture with, gasoline. By 1945 two thirds of world production of butanol and one tenth of acetone were produced by the ABE process.
The developing oil industry and increased cost of the raw materials (generally foodstuffs) meant that butanol from hydrocarbons became more economic, and by the 1960s all ABE plants in Europe and North America had closed. However, the economics were different in China, which really started ABE industry in the 1950s and expanded, peaking in the 1980s, but closing by the end of the century.
The increase in oil prices caused this industry to restart in 2006, reactivating some plants and building new ones. China had the advantage of research and development, when others were not bothering, so it was able to move all to continuous fermentation with its own higher-yield strains.
In the last decade there has been increased world interest in biosynthesis of sustainable fuels and replacements for petroleum, and butanol is a prime candidate. The focus is now on waste materials not in competition with foodstuffs like potatoes and maize.
The fresh air fermenter
The way in which wine turns into vinegar was discovered by Pasteur in 1864. It requires bacteria of the group Acetobacter and oxygen, an aerobic fermentation. Fruit flies (again) help to spread it. While it must have been a disappointment at first, vinegar has been manufactured for thousands of years as a condiment and preservative. A scum often forms on the top of fermenting liquids exposed to air, containing bacteria which has fed on the sugars and ethanol. This, known as “Mother of Vinegar”, has been used to start the process in deliberate manufacture.

Industrial production began in Germany in 1823, reducing production time from months to weeks. The rising chemical industry purified it to acetic acid. The technique of submerged fermentation in the 20th century reduced it to two days. For chemical purposes, acetic acid has been made synthetically since the 1900s.
While it must have been a disappointment at first, vinegar has been manufactured for thousands of years as a condiment and preservative
Mastering the mould
In the 1900s, Pfizer was a US company whose major product was citric acid from Italian lemons and limes for the food and pharmaceutical industry. Unfortunately, WW1 interrupted supplies, so interest arose when a former government chemist, James Currie (1883–), arrived in 1917 with the news that he had discovered certain moulds produced citric acid. This was not an overnight success. In 1919, he got a 16-year-old assistant, Jasper Kane (1903–2004), and the assistance of chemical engineer John Smith (d. 1950). Yields of 50% could be produced in shaking flasks of sugar solution with a common black mould, Aspergillus niger, but it took until 1924 before a full-scale plant for aerobic fermentation had been built and mastered. Fortunately, they were successful, and dominated the market for citric acid. This process is still the main one for citric acid, not least for the millions of bottles and cans of fizzy pop. The company’s hard lessons in large-scale fermentation led to the successful biosynthesis of other products in due course – one in particular will be mentioned in part two of this article.
Read other articles in his history series: https://www.thechemicalengineer.com/tags/chemical-engineering-history
Recent Editions
Catch up on the latest news, views and jobs from The Chemical Engineer. Below are the four latest issues. View a wider selection of the archive from within the Magazine section of this site.




